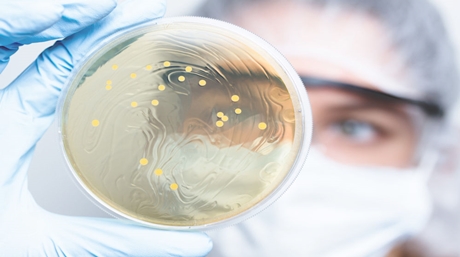
cannabis cultivation lactic acid bacteria

Ready to learn more about the game-changing development in the cannabis industry? Autoflower seeds are making a name for themselves at an astonishing rate and are becoming the leading choice for most marijuana growers.
Today we want to devolve into some fun facts about autoflower seeds that you may not be aware of yet. As they continue to grow in popularity, we hope this will help you uncover the desire to grow them yourself.
What does autoflower mean, and what are these strains? These strains are the product of years of mindful breeding without any genetic modification. Autoflower means that the strain transitions automatically from the vegetative stage to the flowering stage.
The strains are subspecies of Ruderalis combined with a mixture of either Sativa or Indica. Ruderalis is not as common of a strain in the industry due to its low-yielding properties.
However, with thorough cultivation, the successful production of autoflower cannabis has proven that these strains have so much to offer us. There are wide varieties high in THC, CBD, and even those with a pleasant balance.
Thinking of starting your autoflower grow journey? We want to make it easier for you to decide. You may know some of these facts already, but together, they can help you on your path to harvest. Let’s dive into the most fun facts about autoflower cannabis seeds.
If you’re new to the cultivation world, these strains are recommended for beginners. So many experienced growers state that autoflower seeds are their number one choice due to their simplicity and faster production.
Strains like these do not require much maintenance, making them a great option for those looking to learn or desire mass harvests. They are also resilient and able to withstand harsh conditions, such as temperature changes and pests.
With an above-average production rate, you can see why autoflower seeds tend to be more desirable than other strains. These strains can transform from seeds to ready-to-harvest flowers in just ten short weeks. Some say they were able to harvest as many as 5 times a year in the right climates.
Some of you may be skeptical about the yields of each harvest. Indeed, these strains may not produce as much as normal strains. However, when you think of longevity in the overall process, autoflower marijuana can produce substantially greater yields.
As we just mentioned, most growers can harvest multiple times in just a single year! And the reason behind that would be that autoflowering strains are not restricted to light cycles.
This means that autoflower cannabis can produce throughout the year, which is why they are perfect for beginners. It gives them plenty of opportunities to learn and hone their skills as they venture into the growing world.
A big benefit of autoflower cannabis is that these plants require minimal maintenance. Due to their origin from Ruderalis, their genetic makeup allows them to shift into the flowering phase rapidly. And since the plant does this without relying on environmental factors, this makes them low-effort strains.
You must keep them well-watered and maintain their nutritional needs properly. Autoflowers, like our White Widow XTRM, are known to be ready for harvesting as early as in 7 to 8 weeks!
One of the most significant facts about autoflower strains is that they typically don’t grow higher than 1 to 1.2 meters. Since they’re a derivative of Ruderalis, these plants grow smaller in size and have more compact buds.
With that in mind, you can see how this gives the grower the option of discretion and provides a multitude of farming options for them. Possibly the best thing about their compact size is that it allows for easier plant management, which simplifies the growing process.
It is common knowledge that transplantation causes a lot of stress to plants, causing their growth rate to diminish. So, it goes almost without saying that transplantation can be difficult for anyone, especially beginners.
Another place autoflower strains shine is that they do not require transplantation. Once these strains finish the germination phase, they will spread their taproots and begin growing from a seedling into a mature plant in the same spot.
Another amazing fact about autoflower strains is that these guys are the epitome of strength and resilience. And since they’re a product of Ruderalis, they share a few similarities, which makes growing them even easier.
More specifically, autoflower can withstand and survive many conditions. While most strains require special lighting regimens and temperatures and are easily susceptible to pests or diseases. These plants can survive just about any environment, even including colder temperatures which most strains can’t endure.
We’ve covered how resilient autoflower strains are, but what about lighting? Photoperiod strains require lighting cycles to be able to produce. And since autoflower is not a photoperiod strain, it comes in for the win yet again.
These plants can produce buds in all types of lighting, making them practically unstoppable. Whether they receive just a few hours of sun a day or even 24, they continue to grow and produce at all times.
Due to their nature, one of the few difficulties with autoflower is that it cannot produce quality clones. Since these strains grow more quickly than others, cloning isn’t an option.
To produce a good clone, you must cut a small piece of the mother plant, producing an almost exact copy of the plant. However, with autoflower growth rates, the clone will not have time to mature and will end up underdeveloped.
Autoflower seeds are one of the most cost-efficient types possible. We’ve covered their maintenance, lighting needs, resilience, convenience in size, and lack of need for transplantation.
Now, let’s figure in all the costs for farming with photoperiod strains versus all the necessities or lack thereof with autoflower seeds. It’s almost a no-brainer when you think about how cost-effective these plants are.
The resources autoflower strains require are almost the bare minimum. Instead of spending excessive amounts on fertilizer, a good mixture of perlite, coco coir, and compost will do them just right.
And as a bonus, consider the number of harvests yielded multiple times a year. You can easily see that when it comes to autoflower seeds, you get your money’s worth and much more.
We’ve covered many entertaining and educational facts about autoflower seeds. Now you know why so many people are flocking to autoflower seeds. While they have some downsides, the pros outweigh the cons for many growers.
We hope to have offered some insight about these wonderful strains and maybe even encourage you to get started on your own or next autoflower journey. Have you ever tried out autoflower before? Which strain is your favorite, and what makes you like autoflower seeds more than regular or feminized strains?
Feminized marijuana, as the term suggests, refers to marijuana plants that are genetically modified to produce only female plants. The beauty of feminized marijuana seeds lies in their ability to yield female plants almost exclusively. This is a boon for growers because it’s the female marijuana plants that produce the coveted buds. By using feminized seeds, you’re essentially streamlining your cultivation process, ensuring every plant you nurture contributes to your final yield. It’s like having a secret weapon that guarantees a bountiful harvest. However, it’s important to consider the other side of the coin. Feminized seeds may not be as resilient to environmental stress as regular seeds, requiring a bit more care and attention to ensure they thrive. The term ‘feminized seeds’ is simply another name for these specially engineered seeds. In conclusion, the decision to use feminized seeds hinges on your specific needs and aspirations as a grower. If you’re aiming for a more efficient and predictable grow process, feminized marijuana seeds are an excellent choice.
Q1: What are autoflower cannabis strains?
A: Autoflower cannabis strains are bred to transition from the vegetative to the flowering stage automatically, regardless of light cycles. They are hybrids of the Ruderalis subspecies and either Sativa or Indica strains, known for their ease of cultivation and rapid growth.
Q2: How long does it take for autoflower seeds to grow?
A: Autoflower seeds can transition from seeds to ready-to-harvest flowers in about ten weeks. Under optimal conditions, growers can harvest multiple times a year, making these strains highly efficient.
Q3: Are autoflower cannabis plants easy to grow?
A: Yes, autoflower cannabis plants are known for their low-maintenance requirements and resilience. They are ideal for beginners due to their ability to thrive in various conditions without the need for complex light schedules or frequent transplantation.
$ 75,00 – $ 140,00Price range: $ 75,00 through $ 140,00
$ 50,00 – $ 100,00Price range: $ 50,00 through $ 100,00
$ 65,00 – $ 125,00Price range: $ 65,00 through $ 125,00
$ 65,00 – $ 125,00Price range: $ 65,00 through $ 125,00